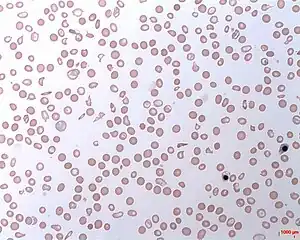

Paroxysmal nocturnal hemoglobinuria
| Paroxysmal nocturnal hemoglobinuria | |
|---|---|
| Other names: Paroxysmal nocturnal haemoglobinuria, Marchiafava–Micheli syndrome[1] | |
![]() | |
| Intravascular hemolytic anemia | |
Paroxysmal nocturnal hemoglobinuria (PNH) is a rare, acquired,[2] life-threatening disease of the blood characterized by destruction of red blood cells by the complement system, a part of the body's innate immune system. This destructive process occurs due to deficiency of the red blood cell surface protein DAF, which normally inhibits such immune reactions. Since the complement cascade attacks the red blood cells within the blood vessels of the circulatory system, the red blood cell destruction (hemolysis) is considered an intravascular hemolytic anemia. Other key features of the disease, such as the high incidence of venous blood clot formation, are incompletely understood.[3]
PNH is the only hemolytic anemia caused by an acquired (rather than inherited) intrinsic defect in the cell membrane (deficiency of glycophosphatidylinositol or GPI) leading to the absence of protective exterior surface proteins that normally attach via a GPI anchor.[4] It may develop on its own ("primary PNH") or in the context of other bone marrow disorders such as aplastic anemia ("secondary PNH"). Only a minority of affected people have the telltale red urine in the morning that originally gave the condition its name.[5]
Allogeneic bone marrow transplantation is the only cure, but has significant rates of additional medical problems and death.[6] The monoclonal antibody eculizumab reduces the need for blood transfusions and improves quality of life for those affected by PNH.[6] Eculizumab dramatically alters the natural course of PNH, reducing symptoms and disease complications as well as improving survival to the extent that it may be equivalent to that of the general population.[7] Eculizumab costs at least US$440,000 for a single year of treatment and has been reported as one of the world's most expensive drugs.[8][9][10]
Signs and symptoms
The classic sign of PNH is red discoloration of the urine due to the presence of hemoglobin and hemosiderin from the breakdown of red blood cells.[11] As the urine is more concentrated in the morning, this is when the color is most pronounced. This phenomenon mainly occurs in those who have the primary form of PNH, who will notice this at some point in their disease course. The remainder mainly experience the symptoms of anemia, such as tiredness, shortness of breath, and palpitations.[5]
A small proportion of patients report attacks of abdominal pain, difficulty swallowing and pain during swallowing, as well as erectile dysfunction in men; this occurs mainly when the breakdown of red blood cells is rapid, and is attributable to spasm of smooth muscle due to depletion of nitric oxide by red cell breakdown products.[12]
Forty percent of people with PNH develop thrombosis (a blood clot) at some point in their illness. This is the main cause of severe complications and death in PNH. These may develop in common sites (deep vein thrombosis of the leg and resultant pulmonary embolism when these clots break off and enter the lungs), but in PNH blood clots may also form in more unusual sites: the hepatic vein (causing Budd-Chiari syndrome), the portal vein of the liver (causing portal vein thrombosis), the superior or inferior mesenteric vein (causing mesenteric ischemia) and veins of the skin. Cerebral venous thrombosis, an uncommon form of stroke, is more common in those with PNH.[5]
Pathophysiology


All cells have proteins attached to their membranes, often serving as a mode of communication or signaling between the cell and the surrounding environment. These signaling proteins are physically attached to the cell membrane in various ways, commonly anchored by glycolipids such as glycosyl phosphatidylinositols (GPI). PNH occurs as a result of a defect in the assembling of these glycolipid-protein structures on the surface of blood cells.[5]
The most common defective enzyme in PNH is phosphatidylinositol glycan A (PIGA), one of several enzymes needed to make GPI. The gene that codes for PIGA is located on the X chromosome, which means that only one active copy of the gene for PIGA is present in each cell (initially, females have two copies, but one is silenced through X-inactivation).[2] A mutation in the PIGA gene can lead to the absence of GPI anchors expressed on the cell membrane. When this mutation occurs in a hematopoietic stem cell in the bone marrow, all of the cells it produces will also have the defect.[5]
Several of the proteins that anchor to GPI on the cell membrane are used to protect the cell from destruction by the complement system, and, without these anchors, the cells are more easily targeted by the complement proteins.[4] Although red blood cells, white blood cells, and platelets are targeted by complement, red blood cells are particularly vulnerable to lysis.[13] The complement system is part of the innate immune system and has a variety of functions, from destroying invading microorganisms by opsonization to direct destabilization by the membrane attack complex. The main proteins that protect blood cells from destruction are decay-accelerating factor (DAF/CD55), which disrupts formation of C3-convertase, and protectin (CD59/MIRL/MAC-IP), which binds the membrane attack complex and prevents C9 from binding to the cell.[5]
The symptoms of esophageal spasm, erectile dysfunction, and abdominal pain are attributed to the fact that hemoglobin released during hemolysis binds with circulating nitric oxide, a substance that is needed to relax smooth muscle. This theory is supported by the fact that these symptoms improve on administration of nitrates or sildenafil (Viagra), which improves the effect of nitric oxide on muscle cells.[5] There is a suspicion that chronic hemolysis causing chronically depleted nitric oxide may lead to the development of pulmonary hypertension (increased pressure in the blood vessels supplying the lung), which in turn puts strain on the heart and causes heart failure.[14]
Historically, the role of sleep and night in this disease (the "nocturnal" component of the name) has been attributed to acidification of the blood at night due to relative hypoventilation and accumulation of carbon dioxide in the blood during sleep. This hypothesis has been questioned by researchers who note that not all those with PNH have increased hemolysis during sleep, so it is uncertain how important a role sleep actually plays in this disease.[15]
Diagnosis

Blood tests in PNH show changes consistent with intravascular hemolytic anemia: low hemoglobin, raised lactate dehydrogenase, raised bilirubin (a breakdown product of hemoglobin), and decreased levels of haptoglobin; there can be raised reticulocytes (immature red cells released by the bone marrow to replace the destroyed cells) if there is no iron deficiency present. The direct antiglobulin test (DAT, or direct Coombs' test) is negative, as the hemolysis of PNH is not caused by antibodies.[5] If the PNH occurs in the setting of known (or suspected) aplastic anemia, abnormal white blood cell counts and decreased platelet counts may be seen at this. In this case, anemia may be caused by insufficient red blood cell production in addition to the hemolysis.[5]
Historically, the sucrose lysis test, in which a patient's red blood cells are placed in low-ionic-strength solution and observed for hemolysis, was used for screening. If this was positive, the Ham's acid hemolysis test (after Dr Thomas Ham, who described the test in 1937) was performed for confirmation.[6][16] The Ham test involves placing red blood cells in mild acid; a positive result (increased RBC fragility) indicates PNH or Congenital dyserythropoietic anemia. This is now an obsolete test for diagnosing PNH due to its low sensitivity and specificity.
Today, the gold standard is flow cytometry for CD55 and CD59 on white and red blood cells. Based on the levels of these cell proteins, erythrocytes may be classified as type I, II, or III PNH cells. Type I cells have normal levels of CD55 and CD59; type II have reduced levels; and type III have absent levels.[5] The fluorescein-labeled proaerolysin (FLAER) test is being used more frequently to diagnose PNH. FLAER binds selectively to the glycophosphatidylinositol anchor and is more accurate in demonstrating a deficit than simply for CD59 or CD55.[6]
Classification
PNH is classified by the context under which it is diagnosed:[5]
- Classic PNH. Evidence of PNH in the absence of another bone marrow disorder.
- PNH in the setting of another specified bone marrow disorder such as aplastic anemia and myelodysplastic syndrome (MDS).
- Subclinical PNH. PNH abnormalities on flow cytometry without signs of hemolysis.
Screening
There are several groups where screening for PNH should be undertaken. These include patients with unexplained thrombosis who are young, have thrombosis in an unusual site (e.g. intra-abdominal veins, cerebral veins, dermal veins), have any evidence of hemolysis (e.g. a raised LDH), or have a low red blood cell, white blood cell, or platelet count.[17] Those who have a diagnosis of aplastic anemia should be screened annually.[5]
Treatment
Acute attacks
There is disagreement as to whether steroids (such as prednisolone) can decrease the severity of hemolytic crises. Transfusion therapy may be needed; in addition to correcting significant anemia, this suppresses the production of PNH cells by the bone marrow, and indirectly the severity of the hemolysis. Iron deficiency develops with time, due to losses in urine, and may have to be treated if present. Iron therapy can result in more hemolysis as more PNH cells are produced.[5]
Long-term
PNH is a chronic condition. In patients with only a small clone and few problems, monitoring of the flow cytometry every six months gives information on the severity and risk of potential complications. Given the high risk of thrombosis in PNH, preventive treatment with warfarin decreases the risk of thrombosis in those with a large clone (50% of white blood cells type III).[5][18]
Episodes of thrombosis are treated as they would in other patients, but, given that PNH is a persisting underlying cause, it is likely that treatment with warfarin or similar drugs needs to be continued long-term after an episode of thrombosis.[5]
Eculizumab

In 2007, the drug eculizumab was approved for the treatment of PNH. Prior to eculizumab, the median life expectancy of an individual with PNH was approximately 10 years. Since that time, short and mid-term studies of patients on eculizumab demonstrate that the drug returns the patient to a normal life expectancy, improves quality of life, and decreases the need for blood transfusions.[7][10]
Eculizumab is controversial due to its high cost, as it is among the most expensive pharmaceuticals in the world, with a price of US$440,000 per person per year.[9]
Eculizumab is a humanized monoclonal antibody that acts as a terminal complement inhibitor. The drug interferes with the formation of the membrane attack complex in erythrocytes by binding to C5, compensating for the loss of protective function that results from CD59 deficiency. This alleviates the primary source of intravascular hemolysis, but it does not reduce the opsonization of erythrocytes caused by CD55 deficiency, so patients who receive this medication often still experience mild to moderate hemolysis.[20]
The U.S. Food and Drug Administration (FDA) has issued a black-box warning as those who take the medication have a 1,000 to 2,000-fold greater risk of invasive meningococcal disease. People on eculizumab are strongly advised to receive meningococcal vaccination at least two weeks prior to starting therapy and to consider preventative antibiotics for the duration of treatment.[21]
Pegcetacoplan
Pegcetacoplan was approved for medical use in the United States in May 2021.[22][23]
Epidemiology
PNH is rare, with an annual rate of 1-2 cases per million.[5] The prognosis without disease-modifying treatment is 10–20 years.[24] Many cases develop in people who have previously been diagnosed with aplastic anemia or myelodysplastic syndrome. The fact that PNH develops in MDS also explains why there appears to be a higher rate of leukemia in PNH, as MDS can sometimes transform into leukemia.[5]
25% of female cases of PNH are discovered during pregnancy. This group has a high rate of thrombosis, and the risk of death of both mother and child are significantly increased (20% and 8% respectively).[5]
History
The first description of paroxysmal hemoglobinuria was by the German physician Paul Strübing (Greifswald, 1852–1915) during a lecture in 1881, later published in 1882.[25] Later comprehensive descriptions were made by Ettore Marchiafava and Alessio Nazari in 1911,[26] with further elaborations by Marchiafava in 1928[27] and Ferdinando Micheli in 1931.[28][29]
The Dutch physician Enneking coined the term "paroxysmal nocturnal hemoglobinuria" (or haemoglobinuria paroxysmalis nocturna in Latin) in 1928, which has since become the default description.[30]
References
- ↑ RESERVED, INSERM US14-- ALL RIGHTS. "Orphanet: Paroxysmal nocturnal hemoglobinuria". www.orpha.net. Archived from the original on 13 May 2023. Retrieved 29 January 2024.
- 1 2 Luzzatto L (August 2013). "PNH from mutations of another PIG gene". Blood. 122 (7): 1099–100. doi:10.1182/blood-2013-06-508556. PMID 23950173.
- ↑ Parker CJ (May 2012). "Paroxysmal nocturnal hemoglobinuria". Current Opinion in Hematology. 19 (3): 141–8. doi:10.1097/MOH.0b013e328351c348. PMID 22395662. S2CID 21266914.
- 1 2 Kumar Vinay; Abbas AK; Fausto N; Mitchell RN (2007). Robbins Basic Pathology (8th ed.). Saunders Elsevier. p. 652. ISBN 978-1-4160-2973-1.
- 1 2 3 4 5 6 7 8 9 10 11 12 13 14 15 16 17 18 Parker C, Omine M, Richards S, Nishimura J, Bessler M, Ware R, et al. (December 2005). "Diagnosis and management of paroxysmal nocturnal hemoglobinuria". Blood. 106 (12): 3699–709. doi:10.1182/blood-2005-04-1717. PMC 1895106. PMID 16051736.
- 1 2 3 4 Brodsky RA (June 2009). "How I treat paroxysmal nocturnal hemoglobinuria". Blood. 113 (26): 6522–7. doi:10.1182/blood-2009-03-195966. PMC 2710914. PMID 19372253.
- 1 2 Wong EK, Kavanagh D (January 2018). "Diseases of complement dysregulation-an overview". Seminars in Immunopathology. 40 (1): 49–64. doi:10.1007/s00281-017-0663-8. PMC 5794843. PMID 29327071.
- ↑ "Alexion Pharmaceuticals ordered to lower price of $500K a year drug in Canada | CBC News". CBC. Archived from the original on 2018-11-26. Retrieved 2018-11-29.
- 1 2 "British watchdog wants U.S. biotech Alexion to justify cost of drug". Reuters. March 3, 2014. Archived from the original on December 26, 2015. Retrieved June 6, 2014.
- 1 2 Martí-Carvajal AJ, Anand V, Cardona AF, Solà I (October 2014). "Eculizumab for treating patients with paroxysmal nocturnal hemoglobinuria". The Cochrane Database of Systematic Reviews. 10 (10): CD010340. doi:10.1002/14651858.CD010340.pub2. PMID 25356860.
- ↑ "Paroxysmal Nocturnal Hemoglobinuria - NORD (National Organization for Rare Disorders)". NORD. 2016. Archived from the original on 30 August 2017. Retrieved 3 July 2017.
- ↑ Rother RP, Bell L, Hillmen P, Gladwin MT (April 2005). "The clinical sequelae of intravascular hemolysis and extracellular plasma hemoglobin: a novel mechanism of human disease". JAMA. 293 (13): 1653–62. doi:10.1001/jama.293.13.1653. PMID 15811985.
- ↑ "Paroxysmal Nocturnal Hemoglobinuria". The Lecturio Medical Concept Library. Archived from the original on 2 August 2021. Retrieved 2 September 2021.
- ↑ Rother RP, Bell L, Hillmen P, Gladwin MT (April 2005). "The clinical sequelae of intravascular hemolysis and extracellular plasma hemoglobin: a novel mechanism of human disease". JAMA. 293 (13): 1653–62. doi:10.1001/jama.293.13.1653. PMID 15811985.
- ↑ Parker CJ (April 2002). "Historical aspects of paroxysmal nocturnal haemoglobinuria: 'defining the disease'". British Journal of Haematology. 117 (1): 3–22. doi:10.1046/j.1365-2141.2002.03374.x. PMID 11918528.
- ↑ Ham TH (1937). "Chronic haemolytic anaemia with paroxysmal nocturnal haemoglobinuria: study of the mechanism of haemolysis in relation to acid-base equilibrium". N Engl J Med. 217 (23): 915–918. doi:10.1056/NEJM193712022172307.
- ↑ Hill A, Kelly RJ, Hillmen P (June 2013). "Thrombosis in paroxysmal nocturnal hemoglobinuria". Blood. 121 (25): 4985–96, quiz 5105. doi:10.1182/blood-2012-09-311381. PMID 23610373.
- ↑ Hall C, Richards S, Hillmen P (November 2003). "Primary prophylaxis with warfarin prevents thrombosis in paroxysmal nocturnal hemoglobinuria (PNH)". Blood. 102 (10): 3587–91. doi:10.1182/blood-2003-01-0009. PMID 12893760.
- ↑ Kim, Insu; Lee, Gyudo; Yoon, Dae Sung (11 April 2019). "Application of Red Cell Membrane in Nanobiotechnology". Erythrocyte. IntechOpen. ISBN 978-1-78984-210-4.
- ↑ Brodsky, Robert A. (2014-10-30). "Paroxysmal nocturnal hemoglobinuria". Blood. 124 (18): 2804–2811. doi:10.1182/blood-2014-02-522128. ISSN 0006-4971. PMC 4215311. PMID 25237200.
- ↑ "Patients Receiving Eculizumab (Soliris) at High Risk for Invasive Meningococcal Disease Despite Vaccination". Centers for Disease Control and Prevention Health Alert Network. 7 July 2017. Archived from the original on 9 July 2017. Retrieved 14 September 2022.
- ↑ "FDA approves new treatment for adults with serious rare blood disease". U.S. Food and Drug Administration (FDA). 14 May 2021. Archived from the original on 14 May 2021. Retrieved 14 May 2021.
- ↑ "Apellis Announces U.S. Food and Drug Administration (FDA) Approval of Empaveli (pegcetacoplan) for Adults with Paroxysmal Nocturnal Hemoglobinuria (PNH)" (Press release). Apellis Pharmaceuticals. 14 May 2021. Archived from the original on 14 May 2021. Retrieved 14 May 2021 – via GlobeNewswire.
- ↑ Pu JJ, Brodsky RA (June 2011). "Paroxysmal nocturnal hemoglobinuria from bench to bedside". Clinical and Translational Science. 4 (3): 219–24. doi:10.1111/j.1752-8062.2011.00262.x. PMC 3128433. PMID 21707954.
- ↑ Strübing P (1882). "Paroxysmale Hämoglobinurie". Dtsch Med Wochenschr (in Deutsch). 8: 1–3 and 17–21. doi:10.1055/s-0029-1196307. Archived from the original on 2020-08-06. Retrieved 2022-09-14.
- ↑ Marchiafava E, Nazari A (1911). "Nuovo contributo allo studio degli itteri cronici emolitici". Policlinico [Med] (in italiano). 18: 241–254.
- ↑ Marchiafava E (1928). "Anemia emolitica con emosiderinuria perpetua". Policlinico [Med] (in italiano). 35: 105–117.
- ↑ Micheli F (1931). "Uno caso di anemia emolitica con emosiderinuria perpetua". G Accad Med Torino (in italiano). 13: 148.
- ↑ Strübing-Marchiafava-Micheli syndrome at Who Named It?
- ↑ Enneking J (1928). "Eine neue form intermittierender haemoglobinurie (Haemoglobinuria paroxysmalis nocturia)". Klin Wochenschr (in Deutsch). 7 (43): 2045–2047. doi:10.1007/BF01846778. S2CID 30149910.
External links
| Classification | |
|---|---|
| External resources |